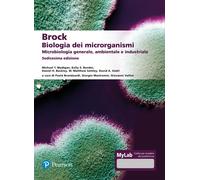

![Microbiologia medica - [EMSI]](https://cdn.prezzo.org/offer/it/microbiologia-medica-emsi-200t1808a3d1c136fe606d42316537eaaa780607b551f82.jpg)

- 1
- 2
- pagina successiva
🤖 Chiedi a ChatGPT
Informazioni su "microbiologia medica"
Con noi puoi confrontare prezzi online per trovare il confronta che più soddisfa le tue richieste "microbiologia medica".
Secondo i tuoi criteri di ricerca "microbiologia medica", il nostro motore di ricerca ha trovato i prezzi più bassi in 24 categorie.
I dati relativi "microbiologia medica"
- Nel complesso, la nostra ricerca ha mostrato 6 differenti online store per il tuo prodotto "microbiologia medica", incluso amazon-marketplace.it, Amazon.it, ebay.it e lafeltrinelli.it.
- In totale, la ricerca del prezzo è stata in grado di individuare 6 offerte, da online shop come per esempio amazon-marketplace.it, Amazon.it, ebay.it e lafeltrinelli.it.
- 7 differenti costruttori offrono il prodotto - edra, Zanichelli, Elsevier e Tickless, che stavi cercando.
- Inoltre, altri clienti hanno anche cercato per il seguente prodotto .
- Con la ricerca del prezzo hai anche la possibilità di scegliere i colori. Puoi selezionare il tuo favorito da 0 ombre. L’articolo viene ordinato soprattutto nel colore .